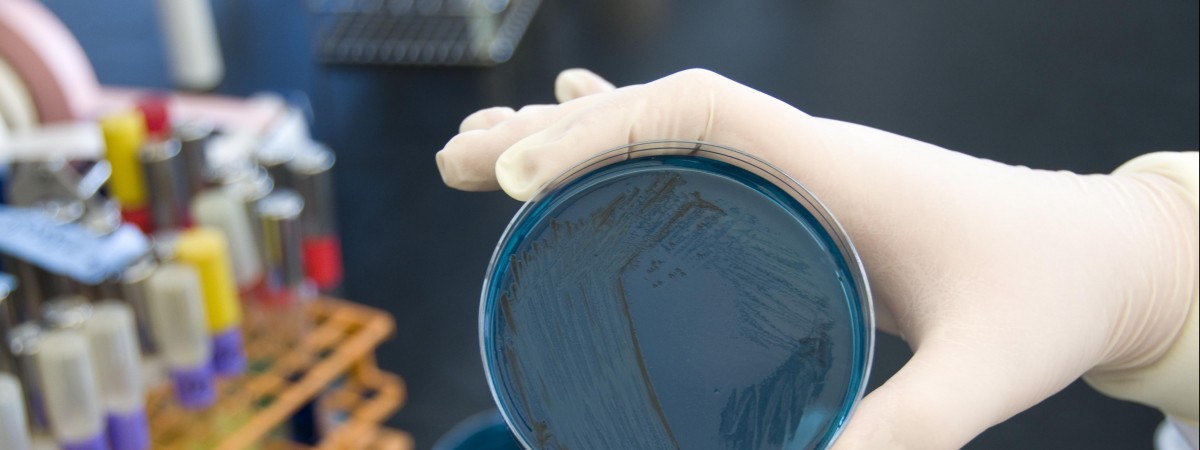
Liczba zarażonych salmonellą rośnie. Źródło bakterii wciąż jest nieznane

Liczba zarażonych salmonellą rośnie. Źródło bakterii wciąż jest nieznane
Badania wskazują, że we wszystkich potwierdzonych przypadkach może chodzić o to samo źródło infekcji. FDA [Public domain]
W związku z rosnącą liczbą zakażeń wszyscy mieszkańcy powinni zwracać szczególną uwagę na niepokojące objawy u siebie i dzieci – należą do nich przede wszystkim biegunka, bóle brzucha, bóle głowy, nudności, a także w niektórych przypadkach gorączka. Do zakażenia dochodzi głównie poprzez jedzenie – w szczególności produkty mięsne, takie jak wieprzowina i drób oraz jajka, mleko czy skorupiaki.
Raport Norwegia
Twoje centrum aktualności i najnowszych wiadomości z Norwegii. Publikujemy dziesiątki informacji dziennie, abyś był zawsze na bieżąco. W jednym miejscu znajdziesz kluczowe informacje: od alertów pogodowych i sytuacji na drogach, przez doniesienia z rynku pracy, po najważniejsze wydarzenia z Oslo, Bergen, Stavanger i wszystkich regionów Norwegii.
06-03-2019 14:13
17
0
Zgłoś